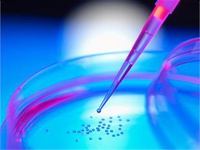
تکثیر سلول‌های پیش ساز عصبی در حجم بالا

پخش زنده
امروز: -
برای سلولدرمانی ضایعات عصبی تولید حجم بالایی از سلولهای پیش ساز عصبی ضروری است
به گزارش خبرگزاری صدا و سیما به نقل از روابط عمومی پژوهشگاه رویان؛ برای سلولدرمانی ضایعات عصبی تولید حجم بالایی از سلولهای پیش ساز عصبی ضروری است، به همین دلیل، پیش از آغاز هر تلاش بالینی لازم است روشی برای تولید سلولهای پیش ساز عصبی با حجم زیاد، در محیطی مشخص و با سرنوشتی منطبق با هدف سلولدرمانی ابداع شود.
به گزارش خبرگزاری صدا و سیما به نقل از روابط عمومی پژوهشگاه رویان؛ برای سلولدرمانی ضایعات عصبی تولید حجم بالایی از سلولهای پیش ساز عصبی ضروری است، به همین دلیل، پیش از آغاز هر تلاش بالینی لازم است روشی برای تولید سلولهای پیش ساز عصبی با حجم زیاد، در محیطی مشخص و با سرنوشتی منطبق با هدف سلولدرمانی ابداع شود.
به منظور یافتن روشی مناسب برای تولید حجم بالای سلولهای بنیادی عصبی، دکتر شیوا نعمتی، نجمه سادات مسعودی و همکارانشان در پژوهشگاه رویان، روشی قدرتمند برای تکثیر سلولهای پیش ساز عصبی در حجم بالا ابداع کردند.
در این روش ابتدا محیط کشتی با ترکیبات مشخص برای تکثیر سلولهای پیش ساز عصبی در حالت شناور پایدار ایجاد شد.
سپس با کشت سلولها در شرایط شناور متحرک (درون ظروف کشت هم زن دار) روش کشت ابداع شده به شرایط جدید تعمیم داده شد. مواردی مانند حجم مناسب محیط کشت، تراکم اولیه سلول ها، تشکیل کرههای سلولی و اندازه آنان در شرایط جدید بهینه شدند.
نتایج این پژوهش که در مجله بین المللی Bioengineering Research به چاپ رسیده است، نشان داد، کرههای سلولی تا بیش از ۱۰ پاساژ تکثیر شدند و در یک دوره پنج روزه حجم آنان ۴ و ۲ دهم برابر شد. در نهایت، پس از پاساژهای متوالی و کشت سلولها در بیوراکتور، بیان ژن و پروتئین در سلولها بررسی و با سلولهای بنیادی عصبی کشت شده در شرایط چسبیده به کف مقایسه شد.
نتایج نشان داد که تکثیر سلولهای پیش ساز عصبی در این روش اثری بر بیان ژن و پروتئین سلولها ندارند و سلولها پس از تکثیر شرایطی مشابه پیش از آن دارند. بنابراین، تولید حجم زیادی از سلولهای پیش ساز عصبی در مدت اندک و با حفظ کیفیت ممکن شد که گامی مهم برای سلول درمانی ضایعات عصبی محسوب میشود.